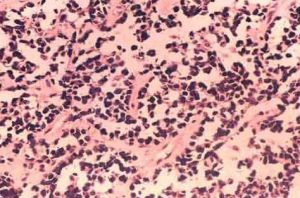
外陰橫紋肌肉瘤 外陰橫紋肌肉瘤

疾病描述
橫紋肌肉瘤是高度惡性腫瘤,是發生於兒童的最常見的軟組織肉瘤,20%發生於盆腔及生殖道。國外研究發現女性生殖道橫紋肌肉瘤約占3.5%。其中外陰橫紋肌肉瘤(占13%)。易發生在大陰唇、陰蒂及尿道周圍。該腫瘤生長快,轉移早。
症狀體徵
常表現為外陰腫脹或進行性增大的塊物,局部疼痛部分呈息肉狀或菜花狀外觀,初起時腫塊較小,位於皮下,可無任何症狀。以後腫塊逐漸增大,侵犯皮膚形成潰瘍,有不規則陰道出血和排液。合併感染時可出現疼痛。同時可有食慾減退、體重下降等全身症狀。患者往往因腫塊、出血和疼痛而就診。有些病例腫塊可在若干年內無變化,而後迅速增大。
臨床分期:
1.IRS 手術病理分組 由國際橫紋肌肉瘤協會組(IRS)制定的分組系統,被普遍採用。
Ⅰ期:腫瘤局限,腫瘤完全切除,區域淋巴結未受侵犯。
Ⅰa 期:腫瘤局限於原發肌肉和臟器。
外陰橫紋肌肉瘤Ⅰb 期:腫瘤浸潤至原發肌肉和臟器之外,如穿過筋膜層。
Ⅱ期:腫瘤局限,肉眼下完全切除。
Ⅱa 期:肉眼下原發腫瘤完全切除,但鏡下切除邊緣仍有殘留病灶,無區域淋巴結轉移。
Ⅱb 期:腫瘤局限,完全切除,有區域淋巴結轉移。
Ⅱc 期:肉眼下原發腫瘤完全切除,但鏡下切除邊緣仍有殘留病灶,有區域淋巴結轉移。
Ⅲ期:不完全切除或活檢,有肉眼下殘留。
Ⅳ期:診斷時有遠處轉移。
2.IRS 術前TNM 分期系統 由於手術,化療和放療在橫紋肌肉瘤治療中的地位逐漸發生改變,而術前的處理會導致手術病理分組的改變。因此,在1997 年IRS 提出了術前TNM 分期系統,根據原發腫塊的部位、大小、局部淋巴結的狀態和遠處轉移情況來確定。在這種術前分期系統中,生殖道橫紋肌肉瘤屬於有利部位,不管腫塊的大小和局部淋巴結的狀態如何,當無遠處轉移時為Ⅰ期,有遠處轉移時為Ⅳ期。因為TNM 分期系統並不能很好地反映預後,所以尚需進一步完善。
3.SIOP 的TNM 分期系統 由國際兒科腫瘤學會SIOP 制訂的。
(1)術前TNM 分期:
Ⅰ期:腫瘤局限於原發組織或器官,無區域淋巴結轉移。
Ⅱ期:腫瘤向周圍1 個或多個組織或器官侵犯,無區域淋巴結轉移。
Ⅲ期:遠處轉移。
(2)術後分期:
pT1:腫瘤局限於原發器官,完全切除,切緣陰性。
pT2:腫瘤向周圍組織或器官侵犯,完全切除,切緣陰性。
pT3:腫瘤不完全切除。
pT3a:顯微鏡下有殘留病灶。
pT3b:有大體殘留或僅做活檢。
疾病病因
外陰橫紋肌肉瘤是一種來源於原始間充質而顯著傾向於肌源性分化的腫瘤。
病理生理
在腺泡型RMS 中,存在著常見的t(2,13)(q35,q14)和t(1,13)(p36,q14)結構性染色體畸變。這種重組在13 號染色體上形成了PAX3/AX7-FKHR 融合基因。PAX3-FKHR 可影響細胞的生長、細胞分化和凋亡。採用反義寡核苷酸途徑下調野生型的PAX3 或PAX3-FKHR 均可誘導RMS 細胞凋亡。這種凋亡途徑非p53依賴,而是通過調節抗凋亡蛋白BCL-XL 的轉錄活性來實現的(Margue 2000)。但Zhao 等(2001)卻認為RMS 的發生不是PAX3-FKHR 融合基因功能的獲得,而是由於FKHR 分化功能的丟失所致。
在70%~100%的胚胎型RMS 中可見到11pl5.5 的等位基因丟失即雜合性缺失,通過串聯重複序列PCR 分析,Barr 等(1997)發現是由於微衛星的不穩定性導致了等位丟失。11p15.5 的等位基因丟失可使該位點的印跡基因擾亂,這些印跡基因是指源自雙親的兩個等位基因中一方不表達或者很少表達的基因。當處於印跡狀態的基因重新表達而呈雙等位基因表達時稱為印跡缺失。目前研究較多的是H19(一種非可讀框架RNA)和IGF2(Ⅱ型胰島素樣生長因子)這一對反向印跡基因。Barr(1997)等認為胚胎型RMS 的發生是由於11p15.5 上一個公認的母系表達的腫瘤抑制基因如H19 的功能丟失,而父系表達的生長促進基因如IGF2 的表達增加所致。在體內,IGF2 和PAX3-FKHR 互相抑制彼此的肌源性分化而導致未分化。未分化的肌母細胞具有了IGF2 所賦予的遷徙能力,這種作用同時被PAX3-FKHR 所增強,通過尚不知道的分子事件導致腺泡型RMS 的發生。胚胎型RMS亦可在IGF2 和PAX3-FKHR 過度表達的情況下進一步發展為腺泡型RMS。
1.病理
(1)大體:按瘤細胞、膠原、黏液樣基質的含量而呈現不同的肉眼形態,且常伴出血、壞死、囊性變、潰瘍形成等繼發性改變。
(2)鏡檢:胚胎型中散在數量不等的典型橫紋肌母細胞,瘤細胞小,分化差,多為圓形、橢圓形,少數細胞為梭形、帶狀或蝌蚪狀,細胞明顯異型且核深染,胞漿豐富,嗜伊紅。瘤細胞傾向於圍繞在血管周圍,細胞排列鬆散,其間有大量的黏液樣基質而膠原量少。葡萄簇型為胚胎型的變型,多發生於黏膜下層,凸向表面形成息肉狀或葡萄狀黏液樣腫塊。通常在上皮下區有緻密的圓形或短梭形瘤細胞區,稱為“形成”層(cambium layer)。腺泡型有低分化圓或卵圓形的瘤細胞不規則聚集而成,周圍有緻密、透明變的纖維間隔分開,中間區細胞失去粘連形成不規則的腺泡樣腔隙,間隔中常有擴張的血管,多核巨細胞常見。也有表現為實性腺瘤狀,與胚胎型較難鑑別,需藉助細胞遺傳學檢查。電鏡下可見胞漿內出現平行相間排列的粗、細肌絲,原始肌節和Z 帶物質等。
(3)特殊染色和免疫組化:典型的RMS 可根據光鏡下磷鎢酸-蘇木精染色證明橫紋的存在。免疫組化的標誌物有多種,其特異性和敏感性各不同。常用的肌蛋白的標誌物包括中間絲蛋白如波形蛋白(vimentin),結蛋白(desmin)和nestin;胞漿蛋白如肌紅蛋白(myoglobin)、肌酸激酶同工酶(CK-MM,CK-BB);收縮蛋白如構成粗肌絲的肌球蛋白(myosin),構成細肌絲的肌動蛋白(actin);調節蛋白如原肌球蛋白,肌鈣蛋白T 和肌彈力蛋白(titin);以及胞核蛋白MyoDl 和myogenin 等。其中骨骼肌特異的指標有肌紅蛋白、肌彈力蛋白、快速型骨骼肌肌球蛋白、MyoDl 和myogenin。肌紅蛋白雖是骨骼肌特有的氧結合蛋白,但只在高分化的橫紋肌母細胞中表達,陽性率低。肌彈力蛋白在RMS 中的陽性表達率因分化程度的不同而不同,可從10.0%~95.0%不等,在梭形細胞型RMS 中肌彈力蛋白為強陽性表達。因為大部分RMS 分化差,所以在眾多輔助診斷RMS 的肌蛋白的標誌物中,MyoDl 和myogenin 是特異性和敏感性均高者,近年來越來越受到重視。尤其對長期中性福馬林固定的標本,MyoDl 較波形蛋白和結蛋白有更高的敏感性,但因為抗原熱修復會增加MyoD1 和myogenin 非特異性的胞漿著色,所以MyoDl 和myogenin 的染色陽性標準須嚴格定位於胞核。Chen 等(1998)發現在腺泡型RMS 中MyoDl 和myogenin 呈強的瀰漫性表達,而胚胎型中則不均勻的極低水平的表達,用MyoDl 和myogenin 可快速、簡單、準確地區分2 種類型的RMS。
2.病理學類型 主要有以下幾種:
(1)傳統的分類:由1985 年Horn 和Enterline 提出,按大體和細胞形態分4 種類型:胚胎型、葡萄簇型、腺泡型和多形型。這種方法被IRS 和WHO 採用。但對未分化的小細胞肉瘤未能分類,而且在組織少時不能確定類型。
(2)細胞組織學分類:又稱Palmer 分類,按核的形態而不是胞漿分化分為混合型、單一圓形細胞型和退行發育型。
(3)國際兒科腫瘤學會(SIOP)分類:以細胞學分化和富於細胞的密度分為胚胎型、腺泡型、多形型RMS 以及胚胎型肉瘤。其中胚胎型RMS 又以分化好壞、葡萄簇有無和緻密或疏鬆分成5 個亞型。
(4)國立癌症研究所(NCI)分類:也分為胚胎型、腺泡型和多形型。但提出了實性腺泡型,並將胚胎型分為平滑肌瘤樣、葡萄簇以及多形性。
(5)橫紋肌肉瘤國際分類(ICR):1995 年提出的一種新的吻合度高且能反映預後的病理學分類方法,一直沿用至今。分為預後較好型包括葡萄簇型和梭形細胞型,預後中等型即胚胎型,以及預後差型包括腺泡型RMS 和未分化型肉瘤,還有目前不能估計預後型包括伴橫紋樣特點的RMS。
診斷檢查
診斷:外陰RMS 無特異性的臨床表現,凡外陰皮下腫塊逐漸增大,尤其短期內迅速增大者,應懷疑為軟組織惡性腫瘤。診斷必須結合針刺活檢或手術切除標本的組織細胞學檢查。診斷時需見紋狀肌細胞,但即使在高分化的RMS 中也常常無明顯的橫紋,而且組織學診斷RMS 主觀性大,誤診率高達40%,所以確診需結合免疫組化和細胞、分子遺傳學檢查。同時需進行X 線平片、陰道B 超、腹部B 超、CT 和磁共振成像(MRI),了解病變部位受累情況。Daldrup 等(2001)通過比較骨骼肌的閃爍顯像,全身MRI 和18F 脫氧葡萄糖正電子發射斷層顯像技術(FDG-PET)來發現RMS 骨髓轉移病灶時發現,(FDG-PET)的敏感性為90%,明顯高於全身MRI和骨骼肌的閃爍顯像,但FDG-PET 顯像亦有假陽性。另外,藉助於宮腔鏡、陰道鏡等監測技術,可協助了解外陰RMS 的局部浸潤情況。
實驗室檢查:
1.組織細胞病理檢查。
2.細胞遺傳學和分子生物學指標 RMS 腫瘤細胞標誌物包括菸鹼樣乙醯膽鹼受體(AchR)γ亞單位、唾液酸化神經細胞黏附分子(PSA-NCAM)、胰島素樣生長因子Ⅱ型(IGF2)等。在用PCR 方法診斷RMS 時,AchR mRNA 比MyoDl 和myogenin更敏感和特異,尤其用α/γAchR<1 作為RMS 的診斷標準時(Gattenloehner1999)。最近,Fine 等(2002)提出eaveolin-3 可作為RMS 的腫瘤標記物。
在腺泡型RMS 中,採用細胞遺傳學方法可檢測到常見的t(2;13)(q35;q14)和t(1;13)(p36;q14)染色體易位,但靈敏度較差。現多採用螢光原位雜交技術(FISH)結合RT-PCR 來檢測由於染色體易位而在13 號染色體上形成的特異的PAX3/PAX7-FKHR 融合基因。54%~87%的腺泡型RMS 中可見PAX3-FKHR,而8%~15%的腺泡型RMS 可見PAX7-FKtHR。
PAX3/PAX7-FKHR 融合基因不僅可輔助診斷腺泡型RMS,而且Athale 等(2001)報導用RT-PCR 檢測骨髓或其他體液中的PAX3/PAX7-FKHR 可發現轉移病灶,其靈敏度為100%,明顯優於傳統的形態學方法。另外,利用PCR 結合限制酶片段長度多肽性分析來發現11p15.5 的雜合性缺失可有助於胚胎型RMS 的診斷和鑑別診斷。
其他輔助檢查:X 線平片、陰道B 超、腹部B 超、CT 和磁共振成像、宮腔鏡檢查。
鑑別診斷
外陰軟組織良性腫瘤:一般發展緩慢,惡性腫瘤發展較快。外陰的腫塊,尤其位於皮下、質地較實者,通常都要做病檢才能做出最後診斷。
治療方案
外陰肉瘤以手術治療為主,輔以抗癌化療或放射治療可望提高療效。
1.手術 外陰胚胎型或葡萄簇型患者在切除或切開活檢後可先予化療,根據對化療的反應再決定手術範圍。對於化療有完全反應者,不必再行局部的手術。但腺泡型的橫紋肌肉瘤無一例外地早期發生淋巴和血行轉移,無論病情早晚,均應根治性外陰切除和腹股溝淋巴結清掃,如腹股溝淋巴結陽性則行髂盆區淋巴清掃術。
2.放療 Ⅰ期胚胎型或葡萄簇型患者放療並無必要。如果誘導化療加再次手術後外陰無殘留疾病,即使Ⅳ期的胚胎型或葡萄簇型患者亦無需放療。但對腺泡型或未分化型即使I 期也應放療,因為放療組較未使用組的10 年疾病緩解生存率明顯高。至於放療的時間,Arndt 等(2001)指出對外陰胚胎型RMS 的Ⅱ期患者,應在化療第3 周開始放療,Ⅲ期的在第9 周開始為佳。放療的量根據對化療的反應而定,對於腺泡型、其他型有顯微或大體殘留的,用±48Gy,而胚胎型如果在化療後體積減少>2/3,放療量±32Gy。
3.化療 以往化療處於輔助地位,用來消除術後殘留病灶。現採用術前多種藥物化療。病期稍晚、組織上核分裂活躍的肉瘤,根治術前後結合化療可改善預後。
(1)目前常用的治療軟組織肉瘤的抗癌化療方案有:
①VAC 方案:長春新鹼(vincristine)1.5mg/m2,靜注,第1,8 天;放線菌素或放線菌素D(更生黴素)400~600μg/m2;靜注,第1~4 天;環磷醯胺(cyclo-phosphamide)300mg/m2,靜注,第1,4,8 天。3~4 周重複使用,但要視骨髓功能恢復情況而定。有報導用此方案治療盆腔肉瘤可延長生存期4~5 倍(Rivard,1975)。
②ADIC 方案:多柔比星(阿黴素)60mg/m2,靜滴,第1 天;達卡巴嗪(氮烯咪胺)(DTIC)250mg/m2,靜滴,第1~5 天。有效率42%(Beretta,1983)。
③CYVADIC 方案:環磷醯胺500mg/m2,靜滴,第2 天;長春新鹼1.5mg/m2,靜注,第1,8 天;達卡巴嗪(氮烯咪胺)250mg/m2,靜滴,第2 天。療程間隔4周。有效率47%。
(2)惡性淋巴瘤病灶局限者,先行手術切除,術後化療,常用方案為:
①COP 方案:環磷醯胺800mg/m2,靜注,第1 天及第15 天;長春新鹼1.4mg/ m2,靜注,第1 天;潑尼松(強的松)100mg,口服,第1~5 天。3 周重複1 個療程。有效率80%以上(潘啟超,1989)。
②CHOP 方案:環磷醯胺750mg/m2。靜滴,第1 天;多柔比星(阿黴素)50mg/m2,靜滴,第1 天;長春新鹼1.4mg/m2,靜注,第1 天;潑尼松(強的松)100mg,口服,第1~5 天。3 周重複1 個療程,有效率達90%以上。
3.放射治療 過去認為外陰肉瘤放射治療無效,然而軟組織肉瘤於根治性手術後補充放射治療是有益的,可減少術後局部復發率,與化療綜合套用也可達到近期治癒。
併發症
常伴有腹股溝淋巴結腫大、感染、出血。
預後及預防
預後:死亡率現已有明顯下降。5 年生存在25%左右。治療後多在1~2 年內出現局部復發,復發者80%以上最終會出現肺轉移。Ariza 曾報導1 例14 歲外陰橫紋肌肉瘤患者在化療和放療後治癒,10 餘年後懷孕並順利分娩。
預防:及早發現,及時治療、做好隨訪。
流行病學
年齡分布廣,年齡8 個月~44 歲,中位發病年齡12 歲。約60%的患者>10 歲,40%的患者>15 歲。
特別提示
及早發現,及時治療、做好隨訪。
醫學疾病任務——婦科
| 婦科是醫療機構的一個診療科目,是婦產科的一個分支專業,是以診療女性婦科病為診療的專業科室。女性生殖系統所患的疾病才叫婦科疾病。婦科疾病的種類可分很多種,本任務包含大多數婦科疾病。 |